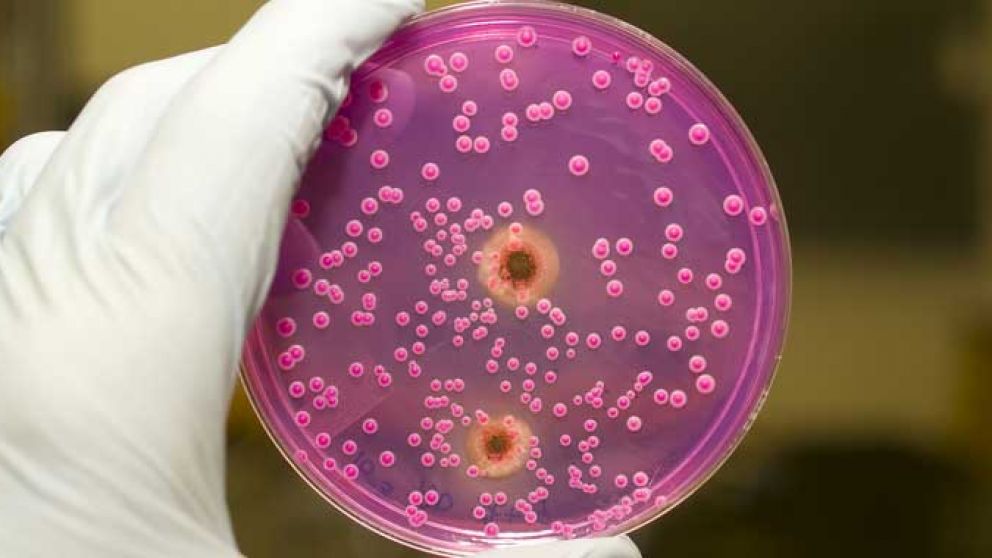
Uno de cada tres pacientes mueren dentro del mes de haber recibido el diagnóstico de una infección invasiva por Candida auris.

Nueva amenaza mundial: candida auris, la posible nueva pandemia
El germen puede colonizarse en pacientes por muchos meses, perdurar en el ambiente y resistir algunos desinfectantes que comúnmente se usan en los centros de atención médica
Mientras el mundo atraviesa la pandemia del coronavirus (Covid-19) la cual dejó hasta el momento a más de 2 millones de víctimas, los Centros para el Control y la Prevención de Enfermedades de Estados Unidos (CDC) alertan sobre una nueva amenaza resistente a los medicamentos, la Candida Auris.
La Candida auris es un hongo que causa infecciones graves y que se propaga en centros de atención médica. Los expertos en prevención de infecciones, así como el personal de atención médica y de laboratorio pueden juntos ayudar a prevenir su propagación, según explicaron los CDC.
El primer caso fue conocido en 2009, aunque se desconoce su origen. El primer paciente en ser tratado por este hongo, era oriundo de Corea del Sur y se le halló en su canal auditivo.
Tiempo después, se registraron casos en India, Sudáfrica, Venezuela, Estados Unidos, Reino Unido y España.
A los expertos les preocupa que este germen es resistente en el medio ambiente; incluso los desinfectantes que se utilizan en hospitales y centros de salud no son efectivos contra este hongo.
En su sitio web, los CDC explican por qué la Candida Auris puede ser un problema. Las cinco razones:
1. Causa infecciones graves. La auris puede causar infecciones invasivas sanguíneas y de otros tipos, especialmente en los pacientes que están internados en hospitales y hogares de ancianos y que tienen muchos problemas médicos. Más de 1 de cada 3 pacientes mueren dentro del mes de haber recibido el diagnóstico de una infección invasiva por C. auris.
2. Con frecuencia, es multirresistente. Los medicamentos antimicóticos que comúnmente se usan para tratar otras infecciones por Candida con frecuencia no tienen efecto en la auris. Algunas cepas aisladas de Candida auris son resistentes a las tres clases principales de medicamentos antimicóticos.
3. Se está volviendo más frecuente. Si bien la auris tan solo se descubrió en el 2009, la cantidad de casos aumentó rápidamente. Desde entonces, se reportaron en docenas de países, incluidos los Estados Unidos.
4. Es difícil de identificar. La C. auris puede ser identificada de un modo erróneo como otro tipo de hongo, a no ser que se usen métodos especializados de laboratorio. Identificar la C. auris correctamente es crucial para dar inicio a las medidas destinadas a detener su propagación y prevenir los brotes.
5. Puede propagarse y causar brotes en centros de atención médica. Como ocurre con otros organismos multirresistentes, como las enterobacterias resistentes a los carbapenémicos (ERC) y los Staphylococcus aureus resistentes a la meticilina (SARM), la C. auris puede transmitirse en los entornos de atención médica y causar brotes. Puede colonizarse en pacientes por muchos meses, perdurar en el ambiente y resistir algunos desinfectantes que comúnmente se usan en los centros de atención médica.